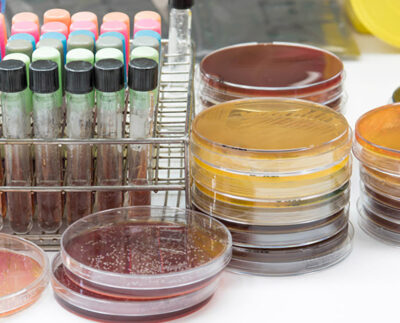

- 26 de abril de 2024
Compreensão científica: A base para a escolha de um probiótico eficiente na alimentação animal
A escolha de um probiótico não deve ser feita ao acaso, especialmente quando se trata da saúde animal. A…
- 1 de novembro de 2023
Em busca de maior eficiência na propriedade pecuária
O Seminário Técnico de Nutrição Animal 2023 abordou diversos temas técnicos e promoveu o lançamento de um inoculante para…
- 14 de setembro de 2023
Tecnologia pioneira e patenteada no Brasil garante nutrição animal de forma homogênea
O Misturador de Ração Acoplado 25.7 RR se destacou na categoria “Novidade Expointer Agricultura de Escala” durante a Expointer,…